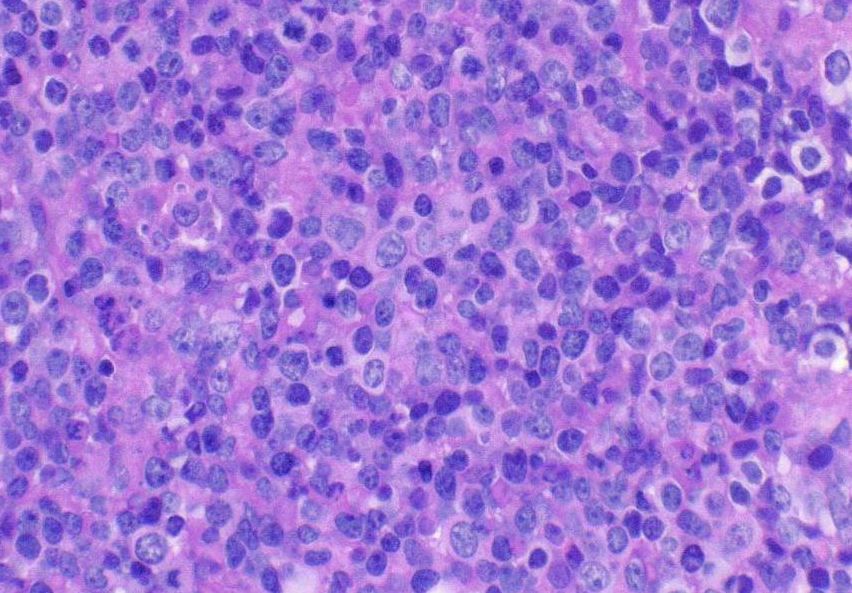

Diseases & Conditions
Primary Lymphoma of Bone
Lymphoma is a cancer that arises from lymphocytes, a type of white blood cell. Although most lymphomas begin in the lymph nodes, the condition can start anywhere in the body. Primary lymphoma of bone (PLB) starts in bone marrow, the spongy tissue inside most bones.
PLB is very rare, accounting for only about 3% of all malignant (cancerous) bone tumors.
In most cases, treatment for PLB involves a combination of chemotherapy and radiation.
Description
The Role of Lymphocytes
Lymphoma is a type of cancer that originates in white blood cells called lymphocytes. Lymphocytes are part of your body's immune system. The two main types of lymphocytes are:
- T lymphocytes (T cells)
- B lymphocytes (B cells)
Both T cells and B cells have specialized roles in helping your body fight infection.
Types of Lymphoma
Lymphoma is classified as one of two main types, based on whether certain unique cells (Reed-Sternberg cells) are there when the tumor is viewed under a microscope.
The two main types of lymphoma are:
- Hodgkin's Lymphoma
- Non-Hodgkin's Lymphoma
Both types of lymphoma are then broken down by doctors even further, based on whether the tumors originate in the body's T cells or B cells.
Most cases of primary lymphoma of bone are a type of non-Hodgkin's lymphoma of B cell origin called "diffuse large B cell lymphoma (DLBCL)." The remaining cases are due to a variety of other lymphoma types.
Primary Lymphoma of Bone
Primary lymphoma of bone is very rare. Cancers that start elsewhere in the body and then metastasize (spread) to bone are much more common than tumors that start in bone.
Patients with PLB may have one or more destructive bone lesions (lesions that destroy healthy bone). These lesions can occur in any bone, but most commonly occur in bones with red bone marrow. This includes:
- Flat bones — such as the pelvis, spine, and ribs
- Long bones — such as the femur (thighbone) and humerus (upper arm bone)
PLB can occur in a person of any age, but it is more commonly diagnosed in people over the age of 30. It affects more men than women.
Cause
The cause of PLB is not fully understood by doctors, but patients who are infected with certain viruses (HIV and Epstein-Barr) and those who have had an organ transplant are at increased risk for developing the condition.
Symptoms
Pain is the most common symptom of PLB. This pain is felt even at rest. Some patients may have swelling or feel a mass in the area of the tumor.
Because PLB destroys healthy tissue and weakens the bone, some patients may break or fracture their bone. This is called a pathologic fracture. Sometimes, people discover their cancer because of a pathologic fracture — when they see a doctor to treat the fracture, the physical exam and/or imaging tests reveal the tumor. Pathologic fractures are most common in weightbearing bones like the pelvis, spine, or femur (thighbone).
Other symptoms of PLB may include:
- Fatigue
- Feeling ill
- Fever
- Night sweats
- Weight loss
In rare cases, neurologic symptoms can develop if a tumor on the spine compresses the spinal cord. Neurologic symptoms may include:
- Shooting pain
- Numbness or tingling in the legs
- Bowel or bladder incontinence
Doctor Examination
Physical Examination
Your doctor will:
- Talk with you about your general health and medical history
- Ask about your symptoms
- Examine the painful area, looking for:
- Tenderness over the bone
- Swelling or a mass
- Enlarged or hard lymph nodes
Your doctor will use imaging and other tests to help diagnosis primary lymphoma of bone.
Laboratory Tests
Your doctors will likely order blood tests to check for any abnormalities (levels that are outside of normal ranges) in your:
- Blood count
- Electrolytes
- Inflammation
- Hormone levels
- Cancer markers
Your doctors may also order blood tests to check for abnormalities in the types and numbers of different cells within your blood. Possible findings include:
- Anemia (low red blood cell count)
- Thrombocytopenia (low platelet count)
Imaging Tests
X-rays. X-rays provide images of dense structures, such as bone. An X-ray of PLB will reveal a mottled (moth-eaten) appearance in the inner part of the bone. There may also be:
- Erosion (small craters or holes) of the bone
- A soft tissue mass or swelling
- Change in the normal shape of the bone due to tumor expansion
The results from your X-rays will help your doctor see whether other types of imaging tests are needed.
Other imaging tests. If your doctor needs more information, they may order additional imaging to help evaluate the tumor.
Other imaging tests may include:
- Computerized tomography (CT) scan
- Magnetic resonance imaging (MRI) scan
- Positron emission tomography (PET) scan
These tests can help your doctor see whether the cancer has spread to other parts of your body or expanded (grown) into nearby soft tissues.
Biopsy. A definitive (final) diagnosis of primary lymphoma of bone is made with a procedure called a bone biopsy. In a bone biopsy, a small sample of the tumor is removed and examined under a microscope.
The procedure can be performed under local anesthesia with a needle or as a small operation using an incision. This procedure may be performed by an orthopaedic surgeon or an interventional radiologist.
When viewed under a microscope, the typical appearance of lymphoma includes many small round blue cells. It can be challenging to make a diagnosis of primary lymphoma of bone. Many special studies are needed to confirm the diagnosis, and some patients need to have more than one biopsy.
Staging
Once your tumor has been identified as PLB, your doctor will conduct more tests to "stage" the tumor.
Tumor stage is determined by several factors, including:
- The size and location of the primary tumor
- Lymph node involvement
- Whether the cancer has metastasized (spread to other parts of the body)
Identifying the stage of the tumor will help your doctor determine the most effective treatment strategy.
Treatment
Chemotherapy
Treatment for PLB almost always includes some combination of multi-agent chemotherapy (CHOP—cyclophosphamide, doxorubicin, vincristine, and prednisone), either with or without radiation. The exact combination of agents used will depend on the results of imaging studies and the stage of the tumor.
An additional agent that specifically targets tumor cells, such as rituximab, may also be added.
Radiation Therapy
Radiation therapy is commonly used to help destroy tumor cells in primary lymphoma of bone. Radiation therapy uses high dose X-ray to kill cancer cells in the bone and help the bone heal. A radiation oncologist manages detailed plans to kill lymphoma cells in a targeted way that helps to preserve normal, healthy cells.
Surgical Treatment
Surgery to remove the tumor is generally not performed in primary lymphoma of bone.
However, some patients may need surgery to stabilize the affected bone (make it secure) in cases where there is a pathologic fracture or an impending pathologic fracture (meaning it will likely happen in the near future). PLB can cause significant pain and immobility; surgery to stabilize the bone can often help decrease pain and improve mobility.
During the procedure, the surgeon inserts metal rods or plates and screws to either fix an existing fracture or prevent bone breakage before it occurs.
Outcome
Your outcome after treatment will depend on several factors, including:
- Your age
- The size, location, and stage of the tumor
- The method of treatment
After treatment, you will meet with your doctor so that they can assess your response to treatment. Regular follow-up appointments are needed to ensure that there are no complications from treatment and that the tumor has not recurred (come back). PLB can come back even many years after treatment, so close follow-up is necessary for all patients diagnosed and treated for lymphoma.
The prognosis (expected outcome) for patients with primary lymphoma of bone varies a great deal, but most tumors respond to multi-agent chemotherapy with or without radiation. Your doctor will talk to you about your specific prognosis.
Contributed and/or Updated by
Peer-Reviewed by
AAOS does not endorse any treatments, procedures, products, or physicians referenced herein. This information is provided as an educational service and is not intended to serve as medical advice. Anyone seeking specific orthopaedic advice or assistance should consult his or her orthopaedic surgeon, or locate one in your area through the AAOS Find an Orthopaedist program on this website.